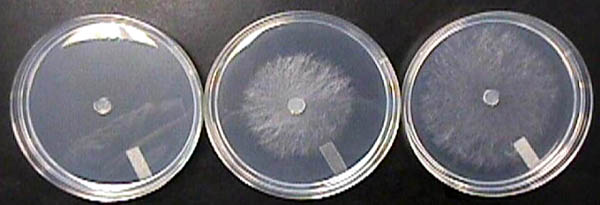
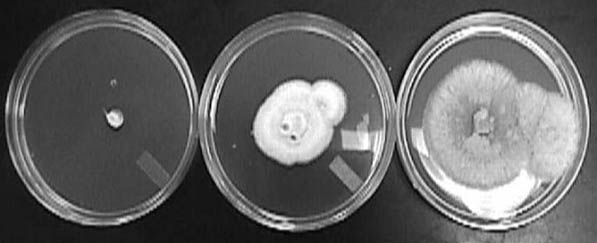
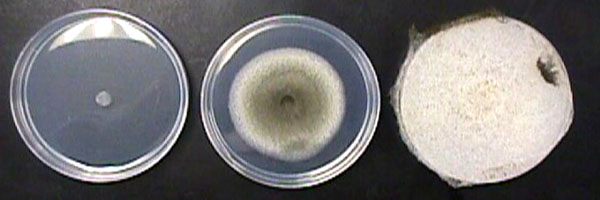

OBJECTIVES:
- To synthesize a plant-produced volatile oil that is readily identified by its odor.
- To explore the ability of the compound to inhibit the growth of fungi in culture.
CLICK HERE FOR INSTRUCTOR'S NOTE 1
MATERIALS:
Synthesis of Methyl Salicylate
- 2 aspirin tablets (325 mg each)
- One test tube
- One glass stirring rod
- Methanol, 3 ml
- Concentrated sulfuric acid (approximately 36 N), 1 ml
- 1 ml pipet equipped with a mechanical pipet filler/dispenser (a 1 ml polyethylene transfer pipet with built-in bulb is an acceptable substitute)
- Boiling water bath
- Sodium bicarbonate solution (4.5 g sodium bicarbonate dissolved in 50 ml water contained in a 250 ml beaker)
Assay of Fungistatic Activity
- Active cultures of the fungi to be tested, growing on solid media (such as Potato Dextrose Agar or Sabouraud Dextrose Agar) in a Petri plate
- 100 mm Petri plates containing a solid medium that supports the growth of the fungi to be tested
- Cork borer, 0.7 cm diameter
- Sterile filter paper (Whatman #2) 4.25 cm circles
- Tape
- 50 μL Micropipettor
- Wrapping film (such as Parafilm M™ or Seal-View™)
- Ruler
PROCEDURES:
Synthesis of Methyl Salicylate
This procedure should be carried out in a fume hood or ventilated work station. Students should wear safety glasses and follow other routine precautions for working with strong acids and flammable organic liquids. Although used as a remedy in traditional medicine, methyl salicylate is toxic if swallowed and may irritate the eyes, respiratory system and skin. Students should limit their inhalational and skin exposure to the compound.
Place 2 aspirin tablets into a test tube. Add 3 ml of methanol and stir until the tablets begin to dissolve. Using a 1 ml pipet equipped with a mechanical pipet filler/dispenser, add 1 ml of concentrated sulfuric acid to the contents of the test tube drop by drop and with stirring. Heat the test tube in a boiling water bath for 10 minutes (no stirring is necessary). After heating, quickly pour the contents of the test tube into the sodium bicarbonate solution in the 250 ml beaker to neutralize the excess acid. Stir the solution thoroughly to ensure that all the acid is neutralized. The methyl salicylate is an oily, slightly brown liquid that spontaneously floats to the surface of the solution; a strong scent of wintergreen should be apparent but the amount of oil will be very small. This protocol should be followed without any aspirin tablets to provide a control treatment for the assay of fungistatic activity that follows.
Assay of Fungistatic Activity
Students should follow aseptic techniques when performing this procedure; working in a sterile environment such as a laminar flow hood will minimize contamination.
Cut mycelial discs (0.7 cm diameter) from the edge of an actively growing colony of the fungus using a sterile cork borer. Place one mycelial disc in the center of a layer of solid fungal growth medium in a 100 mm Petri dish; the mycelial side of the disc should be in contact with the surface of the medium. Tape one circle of sterile filter paper to the inside of the top of the Petri plate. Using a micropipettor, apply 50 µL of methyl salicylate to the filter paper and replace the cover on the plate. Seal the plate with sealing film and incubate at room temperature in ambient light or in darkness. The growth rate of the fungus will determine the length of the incubation period; 1 to 5 days is typical for most fungal species. The cultures should be checked daily and the diameter of the colonies measured before hyphae in the control treatment reach the edge of the plate. Experimental and control plates must be prepared for each fungus that is tested.
Determination of Comparative Growth Inhibition When the growth of the colony on the control treatment nears the edge of the plate, measure the diameters of both the experimental and control colonies to the nearest millimeter using a ruler. If a colony is not perfectly round, measure its diameter at several points and use the mean in the calculation below.
Comparative growth inhibition (CGI) is calculated using the following equation (5)
CGI =100[(Dc – Dt)/Dc] – 100
where Dc is the mean colony diameter for the control and Dt is the mean colony diameter for the experimental treatment. This formula determines the growth inhibition as a percent of the control. Thus, a CGI value of 0 indicates that the growth of the fungus in the experimental treatment was completely inhibited, while a CGI of -100 indicates that the colonies on the control and experimental treatments were the same size. To be fully accurate, 0.7 cm should be subtracted from the diameter of each colony because this was the diameter of the mycelial disc at the beginning of the procedure; this mycelium was already present before treatment and was not subject to inhibition by the fungistatic agent.
CLICK HERE FOR INSTRUCTOR'S NOTE 2
OBSERVATIONS
Eight fungal species (Alternaria tenuis, Aspergillus flavus, Aspergillus niger, Fusarium oxysporum, Neurospora crassa, Penicillium chrysogenum, Penicillium notatum, and
Rhizopus nigricans; Presque Isle Cultures) grown on Potato Dextrose Agar (Difco Laboratories) were tested and shown to work well with the procedures described.
CLICK HERE FOR INSTRUCTOR'S NOTE 3
Figures 1-4 show examples of growth inhibition of several fungi by methyl salicylate
|
|
Figure 1: Inhibition of growth of
Neurospora crassa by methyl salicylate. Left, treatment with commercial methyl salicylate; center, treatment with methyl salicylate synthesized from aspirin; right, control. |
Although most fungi grow from mycelial discs in a uniform manner, some show a tendency to form sectors of more rapidly or more slowly growing hyphae; further, inexperienced students may accidentally touch the mycelial disc to the agar surface creating eccentric growth from the deposition of spores or hyphal fragments. Figure 2 shows the growth of
Aspergillus flavus after five days, and illustrates irregular colonies. Pure methyl salicylate completely inhibited the growth of the fungus while methyl salicylate from aspirin showed a CGI of -67.
|
|
Figure 2: Inhibition of growth of
Aspergillus flavus by methyl salicylate. Left, treatment with commercial methyl salicylate; center, treatment with methyl salicylate synthesized from aspirin; right, control. |
Rhizopus nigricans grows rapidly but was completely inhibited by both pure methyl salicylate and methyl salicylate prepared from aspirin (Figure 3).

|
|
Figure 3: Inhibition of growth of
Rhizopus nigricans by methyl salicylate. Left, treatment with commercial methyl salicylate; center, treatment with methyl salicylate synthesized from aspirin; right, control. |
The fungistasis induced by methyl salicylate is long lasting. Figure 4 shows Alternaria tenuis after 7 days of growth. Although the control is overgrown, the experimental treatment with pure methyl salicylate shows no growth and the treatment with methyl salicylate made from aspirin shows significantly decreased growth.
|
|
Figure 4: Inhibition of growth of
Alternia tenuis by methyl salicylate. Left, treatment with commercial methyl salicylate; center, treatment with methyl salicylate synthesized from aspirin; right, control. |
CONCLUSIONS AND QUESTIONS
Conclusions
The growth of many species of fungi appears to be inhibited by exposure to methyl salicylate (oil of wintergreen). In our studies, all eight species that were tested showed complete inhibition by pure methyl salicylate and showed variable inhibition by methyl salicylate prepared from aspirin. Since not all fungi would be expected to be equally sensitive to the same concentrations of fungistatic compounds, there will be variations in the results depending on the species or specific fungal isolates used. The lack of further purification of the synthetic material is a likely explanation of the difference in its effects when compared to the pure sample. Using a micropipette to draw off the oil meant that the amount of active compound in each sample was variable. Thus, students performing this procedure should be advised to remove the oil carefully, attempting to get as much of it in the sample as possible. Visible inspection of the contents of the pipette tip for the presence of the brown oil may help to ensure consistent results in the bioassay of fungistatic activity.
Questions:
- The procedure described here for production of methyl salicylate involves an overall reaction that includes two acid-catalyzed transesterification reactions between aspirin (acetylsalicylic acid) and methanol. Draw the structures of the reactants and products of the overall reaction.
- The transesterification reactions described in Question 1 are equilibrium dependent. Why, then, is the use of a large excess of methanol important in the overall reaction?
- It is reasonable to hypothesize that fungistasis is a proportional phenomenon; that is, exposure to a larger amount of a fungistatic agent will induce greater inhibition than exposure to a lesser amount. How would you test this hypothesis using the bioassay procedure described here?
- As noted in the Introduction, it may be possible to use volatile oils to control post-harvest diseases of fresh produce such as fresh fruits and vegetables. What problems do you think would be encountered when attempting to put this into practice? Consider both the culinary art and the food science perspectives.
Get the Answers to these Questions
LITERATURE CITED
- Arras, G., M. Agabbio, A. Piga, G. D’hallewin, D. Gerasopoulos, C. Olympios and H. Passam. 1995. Fungicide effects of volatile compounds of
Thymus capitatus essential oil. Acta Horticulturae 379: 593-600.
- Bishop, C.D. and J. Reagan. 1998. Control of the storage pathogen
Botrytis cinerea on Dutch white cabbage by the essential oil of
Melaleuca alternifolia. Journal of Essential Oil Research 10: 57-60.
- Carta, C., M.D.L. Moretti, and A.T. Peana. 1996. Activity of the oil of
Salvia officinalis L. against
Botrytis cinerea. Journal of Essential Oil Research 6: 173-179.
- Caccioni, D.R.L. and M. Guizzardi. 1994. Inhibition of germination and growth of fruit and vegetable postharvest pathogen fungi by essential oil components. Journal of Essential Oil Research 8: 399-404.
- Gwinn, K.D., S.E. Greene, J.F Green, and D.J. Trently. 2004. Host defenses. pages 261-268 In: Plant Pathology. Concepts and Laboratory Exercises. R.N. Trigiano, M.T. Windham, and A.S. Windham (eds.). CRC Press, Boca Raton, FL.
- Jalsenjak, V., S. Peljnjak and D. Kustrak. 1987. Microcapsules of sage oil: essential oils content and antimicrobial activity. Pharmazie 42: 419-420.
- Jandourek, A., J.K. Vaishampayan and J.A. Vazquez. 1998. Efficacy of melaleuca oral solution for the treatment of fluconazole refractory oral candidiasis in AIDS patients. AIDS 12: 1033-1037.
- Jobling, J. 2002. Essential oils: a new idea for post harvest disease control. Sydney Postharvest Laboratory Information Sheet. Found on 12/29/2002 at
http://www.postharvest.com.au/GFV_oils.PDF.
- Quale, J.M., D. Landman, M.M. Zaman, et al. 1996. In vitro activity of
Cinnamomum zeylanicum against azole resistant and sensitive
Candida species and a pilot study of cinnamon for oral candidiasis. American Journal of Chinese Medicine 24: 103-109.
- Singh, H.B., M. Srivastava, A.B. Singh and A.K. Srivastava. 1995. Cinnamon bark oil, a potent fungitoxicant against fungi causing respiratory tract mycoses. Allergy 50: 995-999.
- Stiles, J.C., W. Sparks and R.A. Ronzia. 1995. The inhibition of
Candida albicans by oregano. Journal of Applied Nutrition 47: 96-102.
Acknowledgement: Dr. Monte W. Wolf, Department of Chemistry, Oglethorpe University, provided the protocol for the synthesis of methyl salicylate from aspirin. Dr. Kimberly D. Gwinn, Department of Entomology and Plant Pathology, University of Tennessee, Knoxville, provided the procedure for the bioassay of volatile fungistatic oils and the formula for calculating comparative growth inhibition.
